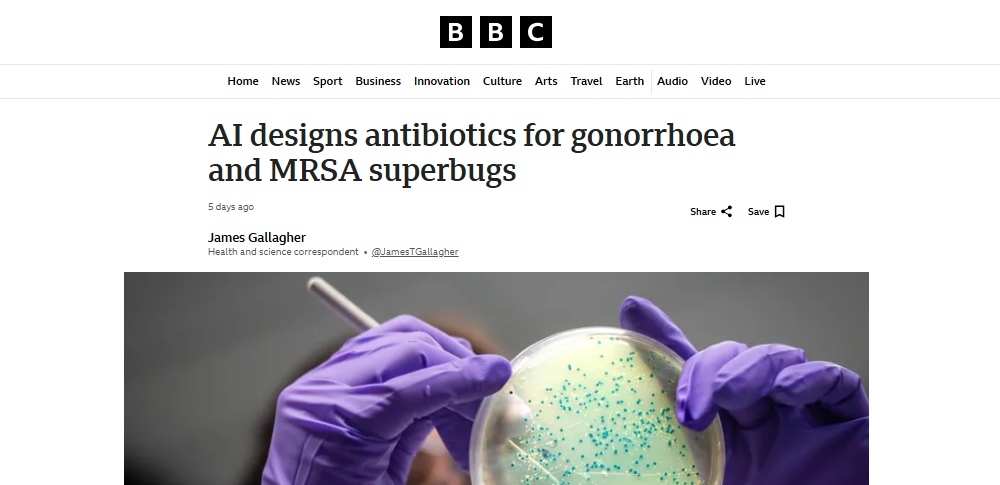

画像:BBCより引用
米マサチューセッツ工科大学(MIT)の研究チームはこのほど、人工知能を用いて新たに二種類の薬剤耐性菌にアプローチできる抗生物質を設計したと発表しました。既に動物実験や試験管内での検証において効果が確認され、淋病菌とMRSA(メチシリン耐性黄色ブドウ球菌)に対して有効性が示されています。
抗生物質は20世紀以降、感染症治療の切り札として多くの命を救ってきました。しかし乱用や過剰処方が原因となり、細菌が薬に適応して効かなくなる「耐性菌」が世界的に拡大し、社会問題となっていました。新しい抗生物質の開発には膨大な工程が必要でしたが、今回の研究では生成AIを使い、分子構造を一から設計する手法に着手。同大がAIに数千万種類の化合物データが与えたところ、細菌の成長を抑える効果や分子構造との関係を学習し、既存薬とは異なる新しい分子を生み出しました。
実際に合成された候補の中で、二つの化合物が淋病菌やMRSAに効果が示されています。マウスを使った実験でも感染症を抑える働きが確認され、抗生物質不足が指摘される中で大きな前進とされています。これらの薬が実際に患者へ処方されるまでには改良と長期間の臨床試験を要しますが、研究者らは、「第二の抗生物質黄金期」を切り開く可能性を持つと期待を寄せています。
参照AI designs antibiotics for gonorrhoea and MRSA superbugs|BBC